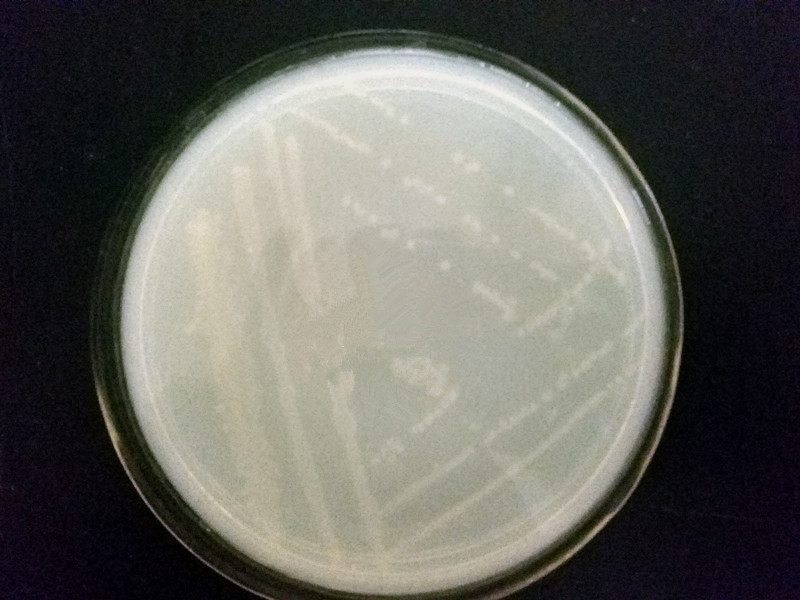

脱氮除磷颗粒污泥中除磷微生物性能分析毕业论文
2020-04-13 11:24:34
摘 要
本文研究了脱氮除磷颗粒污泥系统筛选的Bacillus在生物除磷机理和包埋方面的特性。论文首先从葡萄糖为碳源的SBR反应器中筛选出16株具有除磷效果的微生物,经多次纯化后优选出与四株除磷效率较高的菌株,然后以除磷特性最好的2号菌为研究对象进行菌种鉴定、反硝化特性、生物除磷机理及包埋实验。
研究结果表明,(1)四株菌均有一定的反硝化能力。硝氮浓度为277mg/L时,四株菌脱氮效率在20%~30%范围内;硝氮浓度为27.7mg/L时,四株菌脱氮效率在36%~45%范围内;(2)2号菌属芽孢杆菌属(Bacillus);(3)分别以葡萄糖和醋酸钠为碳源时,Bacillus在厌氧条件下合成PHB和糖原,在好氧条件下分解PHB和糖原,PHB和糖原含量变化规律一致;(4)5mg/ml的聚电解质和3mg/ml的聚多巴胺包埋Bacillus使除磷效率下降。
关键词:聚磷菌;测序;PHB;包埋
Abstract
In this paper, the characteristics of Bacillus isolated from synchronous nitrogen and phosphorus removal granular sludge system were studied on biological phosphorus removal mechanisms and immobilization. This paper firstly screened 16 strains of phosphorus accumulating organisms from SBR reactor with glucose as carbon source, selected four stains with highest efficiency after beening purified several times,then choose No.2 bacteria to identify its species,study its ability of denitrification, biological phosphorus removal mechanisms and characteristics after immobilization.
The results showed that(1) four strains had certain denitrification ability. The denitrification efficiency of the four strains was within 20%~30% range with 277mg/L nitrate nitrogen in solution, while the efficiency was within 36%~45% range with 27.7mg/L nitrate nitrogen in solution.(2) no. 2 bacterium belongs to Bacillus sp. (3) when glucose and sodium acetate were used as carbon sources respectively, Bacillus synthesized PHB and glycogen in anaerobic conditions, and decomposed PHB and glycogen in aerobic conditions. (4) Bacillus immobilized with 5mg/ml polyelectrolytes and 3mg/ml polydopaminergic resulted to decrease of the phosphorus removal efficiency.
Key Words:Phosphate-accumulating organisms;sequencing;PHB;immobilization
目 录
第1章 绪论 1
1.1 研究背景 1
1.2 聚磷菌的研究现状 4
1.2.1 聚磷菌的两种除磷机理 4
1.2.2几种常见的聚磷菌的特性 6
1.3 固定化微生物技术 8
1.3.1 固定化微生物技术介绍 8
1.3.2 聚磷菌的包埋 9
1.4 课题的研究目的及技术路线 10
1.4.1 课题研究的目的及意义 10
1.4.2 研究内容 10
1.4.3 研究技术路线 11
第2章 实验材料与方法 12
2.1 聚磷菌的筛选 12
2.1.1实验方法 12
2.1.2 实验材料 13
2.2 聚磷菌特性研究实验 14
2.2.1 聚磷菌鉴定 14
2.2.2 反硝化特性 16
2.2.3 包埋实验 17
2.3 其他实验方法 18
2.3.1 PHB的测定 18
2.3.2糖原的测定 20
2.3.3 其他测试方法 21
第3章 聚磷菌的筛选及测序研究 28
3.1聚磷菌的筛选结果及分析 28
3.2 聚磷菌菌种的鉴定结果及分析 30
第4章 Bacillus的代谢机理研究 35
4.1 不同碳源条件下Bacillus体内PHB的变化 35
4.2 不同碳源条件下Bacillus体内糖原的变化 37
4.3 碳源对Bacillus特性的影响 37
第5章 Bacillus固定化技术研究 39
5.1 聚电解质对Bacillus性能的影响 39
5.2 聚多巴胺对Bacillus性能的影响 41
第6章 结论与建议 43
6.1 结论 43
6.2 建议 43
参考文献 44
致 谢 47
第1章 绪论
1.1 研究背景
大量富含氮、磷的废水未经处理或处理不达标排入自然水体,已经加剧了的水体富营养化严重程度,影响了水质环境,破坏了水体生态系统的平衡,致使水体中原生后生动物的死亡,藻类大量繁殖,严重影响了城市取水。国际上一般认为,湖水中总磷浓度为0.02mg/L,总氮浓度为0.2mg/L会导致水体富营养化的发生[1]。水体富营养化的问题已经引起了研究者的广泛关注,深入开发了较多的废水脱氮除磷的工艺来控制污水中氮磷含量,降低对受纳水体富营养化的影响。
常见废水脱氮除磷的工艺有:Anaerobic/Anoxic/Oxic(简称A2O),UCT(University of Cape town)工艺,Bardenpho工艺,Phoredox工艺,MUCT工艺等。现具体介绍三种工艺:
- A2O工艺
A2O工艺,即厌氧-缺氧-好氧法,是70年代,美国人在Anaeroxic-Oxic(简称An-O法)的基础上开发出来的[2]。工艺流程如图1.1所示:
|
图1.1 A2O工艺流程图 |
原污水和回流污泥同时进入厌氧反应器,该反应器内主要发生释磷和部分有机物氨化。厌氧反应器的出水进入缺氧反应器,该反应器主要发生脱氮,硝氮通过内循环由好氧反应器送来,内循环流量一般为2Q。混合液从缺氧反应器出来后进入好氧反应器,该反应器内发生BOD去除、硝化反应和磷的摄取等反应。沉淀池发生泥水分离,污泥部分回流,部分排走,上清液作为处理水排放。
A2O工艺是较为简单的同步脱氮除磷工艺。在厌氧(缺氧)、好氧交替运行下,丝状菌的生长被抑制,不能大量繁殖;污泥含磷浓度较高,可以回收利用;运行费用较低。但A2O工艺的除磷率和脱氮率很难进一步提高。
- UCT工艺
UCT工艺是南非开普敦大学开发的类似于A2O工艺的一种脱氮除磷工艺。工艺流程如图1.2所示:
|
图1.2 UCT工艺流程图 |
UCT的反应器类型及顺序与A2O相同,不同之处在于:(1)污泥回流到缺氧反应器前端,可以防止污泥中的NO3-进入厌氧反应器破坏厌氧状态,从而影响厌氧释磷;(2)经缺氧反应器的反硝化作用,缺氧液中NO3-浓度较低,回流到厌氧反应器前端,不会破坏厌氧状态,且缺氧液中含有较多溶解性的BOD,有利于微生物的利用。
UCT工艺降低了厌氧反应器的硝酸盐浓度,提高了磷的去除率,同时未影响到氮的去除,实现了同步脱氮除磷。一般该工艺的脱氮率和除磷率都大于70%。
- Bardenpho工艺
Bardenpho工艺是以高效同步脱氮除磷为目的而开发的技术,工艺流程如图1.3所示:
|
图1.3 UCT工艺流程图 |
Bardenpho工艺共有两个厌氧反应器和好氧反应器。原污水进入第一厌氧反应池,主要发生反硝化脱氮,其次释磷。消化液来自第一好氧反应器的内回流,含磷污泥来自沉淀池。第一好氧反应器主要去除BOD,其次发生硝化和吸磷。由于该单元BOD浓度较高,所以硝化程度低。第二厌氧反应器主要发生释磷,其次发生反硝化脱氮。第二好氧反应器主要发生吸磷、去除BOD和硝化。
各反应器都有主要的功能,并兼行其他功能。无论哪一种反应,在该系统中都至少进行了2次。所以Bardenpho工艺的脱氮除磷效果很好,脱氮率达90%~95%,除磷率达97%。但该工艺较为复杂,反应器数量多,运行繁琐,成本较高。
以上是毕业论文大纲或资料介绍,该课题完整毕业论文、开题报告、任务书、程序设计、图纸设计等资料请添加微信获取,微信号:bysjorg。
相关图片展示: